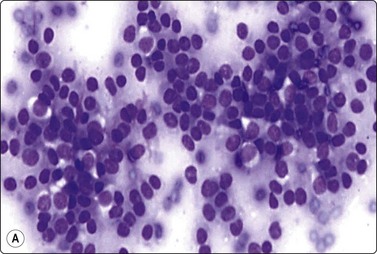
image

CHAPTER 13 Male and female genital tract
Male genital tract, prostate and testis
Miguel Perez-Guillermo
Introduction
Transrectal fine needle aspiration (tFNA) of the prostate was introduced in 1960.1 In Europe, tFNA was the technique of choice for investigating palpable abnormalities of the prostate for more than two decades. It became popular in the United States only later, in the 1980s.2-4 Despite the initial success, tFNA has been gradually superseded by the biopsy-gun technique and pathologists who trained after 1990 generally have had little experience with tFNA of the prostate.5 Thin-needle core biopsy (TNCB) yields thin 15–20 mm-long tissue cylinders, which provide Gleason scores for prostate cancer based on histopathology, as required by urologists. However, the predictive value of TNCB in selecting patients for radical prostatectomy (RP) has been brought into question.6 In one study, only 55% of patients who met the criteria for RP had tumors that were organ confined.7 The utility of tFNA of palpable lesions of the prostate,5,8,9 and its continuing role into the twenty-first century have been discussed elsewhere.10 A promising future for tFNA has been foretold.11
Testicular germ cell tumors (TGCT) usually present as a nodule or painless swelling of one testicle. A dull ache or heaviness in the scrotum or lower abdomen, and a swelling mistaken for epididymitis may be the presenting symptoms.12 Incisional biopsy is contraindicated because of the risk of spread, locally and to regional lymph nodes. Ultrasonography (US) is the primary imaging modality for investigating scrotal pathology.12,13 Serum tumor markers (STM) may be helpful.12 However, scrotal content pathology still poses diagnostic problems for urologists. US and STM are not readily accessible in some countries. The impact of delay, by patients or healthcare providers, in the diagnosis of testicular cancer has been addressed by several authors.14-16 Diagnostic delay is highly correlated with stage and survival in non-seminomatous TGCT.16
In experienced hands, the information provided by FNA is more useful than that provided by US and STM. FNA can avoid the ‘shuttle syndrome’ and the ‘wait and see’ approach. We and others believe that FNA has an important place in the diagnosis of intrascrotal pathology and in the evaluation of male fertility.17-25
The same technique as for tFNA of the prostate can be used to biopsy lesions of the female genital tract via the vagina or rectum. A detailed account of clinical applications and limitations of transvaginal and tFNA in gynecology can be found elsewhere.26
Prostate
Clinical aspects
The place of FNA in the investigative sequence
The utility and practice of tFNA of the prostate and the reasons for its success in our hospital have been reported previously.8-10 Provided the pathologist is able to pinpoint nodules and indurations of the prostate by palpation with the index finger, and has dexterity in performing tFNA, the results of FNA match those obtained by TNCB.10
The three-tiered cytological classification for grading prostate cancer proposed by Esposti27 has been shown to have prognostic value. An estimation of Gleason score can also be made on tFNA samples.10 As recently as 2007, Maksen et al.5 stated that gland size roughly determines Gleason pattern in liquid-fixed FNA samples. Prostatic intraepithelial neoplasia (PIN) should not be diagnosed by FNA alone. However, a highly cellular smear with pronounced atypia seems to rule out PIN.28 Immunostaining has proven useful in FNA of the prostate.5,29
tFNA is likely to continue to be used in view of economic considerations and recent health budget restraints because it is a simple and comparatively much cheaper technique than TCNB. We acknowledge that nowadays tFNA has been relegated in most Western countries, but it may still play a key role in developing countries.
Indications
Accuracy of diagnosis
Transrectal fine needle aspiration and US-guided TNCB using automated biopsy devices have a high and essentially equal accuracy in diagnosing prostate cancer.4,5 A recent review of the literature10 produced a list of references commenting on the correlation between cytological grading and Gleason score and the accuracy of digitally guided tFNA compared with thick and US-guided TNCB. Prerequisites for acquisition of an acceptable level of competence in performing tFNA and interpreting the smears have been defined.34
Tannenbaum et al.4 and Maksen et al.5 have described the features of benign prostatic cytology, the sources of atypical cells, the cytology of carcinoma, and the causes of false-negative and false-positive cytological diagnoses in liquid-fixed FNA collections, and Willems et al.34 in conventional smears. The most common cause of a false-negative FNA is an inadequate sample. Dexterous pathologists rarely make a false-positive diagnosis. We have previously commented on the diagnostic challenges posed by atypical cells in smears of granulomatous prostatitis8 and on pitfalls and infrequent findings in FNA of the prostate.9 Basic rules to avoid pitfalls in FNA in different contexts have been put forward.35 See also Chapter 5 in the seminal monograph by Zajicek36 and Chapter 11 in the book by Linsk and Franzén.37
Complications
The rare complications of tFNA were analyzed in a review of 14 000 patients with follow-up.38 Transient hematuria is not uncommon. Fever may develop within 24 hours. Patients should be instructed to report promptly in both situations. In our experience of more than 10 000 tFNAs (using 23-gauge needles), no tumor seeding in the needle track has been observed after 5 to 10 years’ follow-up.
Contraindications
The only contraindication is symptomatic febrile prostatitis.36 We have performed tFNAs in patients with inadvertent acute prostatitis without complications. tFNA can be performed in patients with hemorrhagic diathesis and in patients on anticoagulation therapy.
Technical considerations
Patients should be verbally informed of the whole procedure by the examining pathologist and a written informed consent requested. No special preparations for biopsy and no sedation are necessary. tFNA is carried out as an outpatient procedure. A urological lubricant helps to introduce the palpating finger. The most comfortable position for both patient and examining pathologist is the lithotomy position on a gynecological examination couch (Fig. 13.1A,B). A rapid feedback to urologists is essential to achieve success.


Fig. 13.1 t-FNA of the prostate
(A) The Franzén guide fitted to the left index finger covered with a finger cot; (B) Performing a tFNA of the prostate.
Appropriate training should ensure that the operator properly masters the technique of tFNA using the Franzén guide and a 20-cm long 23-gauge needle fitted to a disposable syringe and a Cameco holder (Cameco AB, Box 5519, Täby, S-183 05 Sweden, Pat no. 3819091). This is essential to minimise the proportion of unsatisfactory specimens and to increase the accuracy of the procedure. The examining pathologist must be proficient in digital examination of the prostate. Details about the biopsy technique can be found elsewhere.34,37
We perform one or two tFNAs from each abnormal palpable zone; additional aspirates are taken from the opposite lobe even if apparently normal on palpation. This approach enables us to suggest at least a T2C stage if cancer cells are found in aspirates from both lobes. We use Diff-Quik (DQ)™ and Pap stain in parallel.
The gross aspect of the yield may predict the diagnosis even before microscopic examination: abundant, granular yield suggests carcinoma; a drop of blood-tinged fluid with particulate material suggests hyperplasia; hemorrhagic yield indicates that the needle is out of the prostate; a ‘non-representative’ smear obtained by a dexterous operator suggests stromal hyperplasia; abundant fluid suggests either urine or a cyst.
The importance of proficient training in smearing and distributing the yield onto several slides cannot be overemphasised (see Chapter 2). The three-step smearing technique is recommended for fluid yields in order to concentrate solid fragments into two bands. The yield is suitable for molecular studies.
Cytological findings
Benign prostatic hyperplasia (BPH) (Fig. 13.2)4,5,34,36,37,39

Fig. 13.2 Prostate, benign hyperplasia
Honeycomb-like sheets of uniform glandular epithelial cells; note visible cell borders and coarse cytoplasmic granules in A (A, DQ; B, Pap, HP).
Cohesive monolayered sheets of glandular epithelial cells can be quite large with distinct boundaries; most cells are seen on end and appear polygonal with centrally placed nuclei. The abundant pale cytoplasm and the distinct cell membranes give the sheet a honeycomb appearance (Fig. 13.2A,B). Only at the periphery are some cells seen in profile as columnar.
The main criteria of benignity are the uniform distribution of nuclei within monolayered sheets, distinct cell membranes, low N : C ratio and intracytoplasmic secretory granules (Fig. 13.2A). The granules stain dark magenta with DQ but are less conspicuous in alcohol-fixed Pap-stained smears. Although granules are not present in all benign epithelial cells, they are rarely present in carcinoma cells and absent in epithelial cells from rectal mucosa.
Other common findings in smears of BPH are: inflammatory cells, macrophages, metaplastic squamous epithelial cells, clumps of condensed secretion, fragments of calculi and corpora amylacea. Tiny fragments of stromal smooth muscle tissue are sometimes seen. Cytologic features of the central zone have been described in scrape smears of surgical specimens.40
Prostatitis (Figs 13.3 and 13.4)4,36,37,39

Fig. 13.4 Prostatitis (granulomatous)
Many epithelioid histiocytes, multinucleated giant cell with phagocytosed secretion; many neutrophils (DQ, IP).
Mild epithelial atypia is acceptable in the presence of significant inflammation (Fig. 13.3). The distribution of cells in epithelial sheets may be less regular than normal and the cell membranes less distinct. Nuclei may be mildly enlarged and varying in size. Cytoplasmic granules are often absent, while degenerative changes such as cytoplasmic vacuolation are often seen. However, prominent nuclear enlargement and pleomorphism, nucleolar enlargement and chromatin abnormalities do not occur. There is little tendency to dissociation of epithelial sheets, and microacini are not seen. As inflammation may coexist with carcinoma, epithelial atypia must be carefully evaluated. We require the presence of epithelial sheets encrusted with polymorphonuclears to arrive at the diagnosis of acute prostatitis.
Granulomatous prostatitis (Fig. 13.4)36,37,39 remains a diagnostic dilemma since both clinical and cytological findings may mimic carcinoma. The cytological diagnosis of non-specific granulomatous prostatitis or tuberculous prostatitis, respectively, is based on the presence of epithelioid granulomas or obvious caseous necrosis. Nuclear overlapping, anisonucleosis, occasionally striking atypia, naked nuclei and some acinar formation may result in a false-positive diagnosis. Epithelial atypical cells in granulomatous prostatitis show a typical basophilia in DQ-stained smears; this basophilia is not seen in prostate carcinoma cells.
The diagnostic challenges posed by epithelioid aggregates and reactive changes in both duct/acinar and metaplastic cells have been discussed elsewhere.8
The cytological findings in malacoplakia of the prostate by FNA have been described.41
Adenocarcinoma of prostate (Figs 13.5-13.8)4,5,27,34,36,37,39



Fig. 13.5 Well-differentiated adenocarcinoma
Cohesive sheets of atypical glandular epithelium; mild nuclear enlargement and anisokaryosis; crowding of nuclei; absence of cytoplasmic granules. Note microacinar pattern in B and prominent nucleoli and a mitotic figure in C (A and B, DQ; C, Pap, HP).

Fig. 13.6 Moderately-differentiated adenocarcinoma
Aggregate of malignant cells; marked nuclear enlargement and nuclear pleomorphism; nuclear crowding; microacinar pattern: indistinct cell borders. Note contrasting honeycomb sheet of benign epithelium (DQ, HP).

Fig. 13.7 Moderately-differentiated adenocarcinoma
Cellular smears of less cohesive malignant glandular epithelial cells; vesicular nuclei; prominent nucleoli. Note fragile vacuolated cytoplasm suggestive of a clear cell pattern in B (A, Pap; B, DQ, HP).

Fig. 13.8 Poorly-differentiated adenocarcinoma
Poorly cohesive malignant cells with large vesicular malignant nuclei and large nucleoli. Note small sheet of benign epithelium on right in A (A, DQ; B, Pap, HP).
Criteria for diagnosis
In smears of prostatic carcinoma, sheets of benign glandular epithelial cells are commonly seen side-by-side with aggregates of malignant cells (Fig. 13.6), reflecting the diffusely infiltrative growth of the tumor. Benign and malignant cells can be directly compared (very helpful clue) and differences in cytoarchitectural features are easily appreciated. Nuclear enlargement is one of the most important criteria of malignancy. Nucleolar enlargement is better demonstrated in Pap-stained smears.
Absence of visible cell membranes, nuclear crowding and overlapping and dissociation of cells are other important criteria. The presence of coarse intracytoplasmic secretory granules makes malignancy unlikely, but they can occasionally be found in cells from well-differentiated adenocarcinoma. Cytoplasmic vacuolation may be seen in both benign and malignant cells. Nuclear pleomorphism and chromatin abnormalities are obvious in less well-differentiated cancers but may be subtle in well-differentiated carcinomas, rendering a definitive malignant diagnosis difficult (Fig. 13.5). Demonstration of basal epithelial cells by immunocytochemistry may be of help in the distinction between well-differentiated adenocarcinoma and adenosis or basal cell hyperplasia,5 but interpretation is more difficult than in histologic sections. Immunostaining is a useful tool for the diagnosis of prostate cancer at metastatic sites.42 Results may be conflicting in metastases of poorly differentiated carcinomas.
If only a small number of atypical cells are found in a predominantly benign cell population, great caution should be observed in making a definitive diagnosis of malignancy. Sources of atypical cells have been referred to elsewhere.4,5,8,9 In case of doubt, the patient should be submitted to systematic TNCB taken according to a standardized protocol.
Regarding cytological grading of prostatic adenocarcinoma, see below and Figures 13.5 to 13.8.
Not infrequently, smears from BPH contain a few cohesive aggregates of cells with frank atypia that may represent PIN, basal cell or atypical hyperplasia, and can be mistaken for malignancy (Figs 13.9 and 13.10). However, they fall short of clear-cut criteria of malignancy; cell cohesion is maintained and microacini are rarely seen. The atypical cells usually constitute only a minor proportion of the cell population. The presence of nucleolar enlargement in some cells should not lead to the diagnosis of carcinoma since they may correspond to focal atypical hyperplasia.

Fig. 13.9 Basal cell (atypical) hyperplasia
Sheets of glandular epithelial cells showing mild nuclear enlargement and nuclear crowding contrasting with normal epithelium (A, DQ; B, Pap, HP).
PIN should not be diagnosed by tFNA alone.28 We use the term ‘atypical cells’ when the atypia and cellularity are below the requirements needed to reach a confident diagnosis of malignancy, and submit the patient for systematic TNCB. Histology of these cases almost always reveals either high-grade PIN or low-grade carcinoma. Pathologists should refrain from making a definitive diagnosis of malignancy when the smears contain only a small proportion of cells with malignant features.
Contamination of samples by epithelial cells from the rectal mucosa is common when tFNA is performed by an inexperienced operator.36,37 Isolated tall cylindrical cells, palisaded rows, glandular structures and goblet cells intermingled with mucin and rectal content indicate rectal mucosal origin. Rectal cells lack intracytoplasmic granules (Fig. 13.11).

Fig. 13.11 Rectal contamination
Microglandular aggregates and palisading columnar epithelial cells; some mucin (DQ, IP).
Inadvertent aspiration of the seminal vesicle may yield large atypical cells that may mislead the unwary into an erroneous diagnosis of poorly differentiated carcinoma. Large hyperchromatic, often multilobated, pleomorphic, even bizarre, nuclei are seen.9,36,37 Coarse intracytoplasmic granules of lipofuscin, which stain dark green–blue with DQ, brown with Pap or H&E, quite different from the secretory granules of prostate epithelium (Figs 13.12 and 13.13), dense aggregates of basophilic amorphous material and spermatozoa in the background indicate origin from seminal vesicle.

Fig. 13.12 Seminal vesicle epithelium
(A) Large bizarre nuclei; note occasional spermatozoa in the background (arrow) (DQ, HP); (B) Single epithelial cells with large pleomorphic nuclei; note coarse intracytoplasmic pigment (DQ, HP).


Fig. 13.13 Seminal vesicle epithelium
(A) Vaguely glandular aggregates of epithelial cells with pleomorphic and hyperchromatic nuclei; abundant cytoplasm with vacuoles and brown pigment granules (Pap, HP); (B) Corresponding tissue section (H&E, HP).
Ganglion cells may mimic malignant cells (Fig. 13.14).9

Three large ganglion cells with prominent nucleoli next to a cluster of malignant cells. Notice a malignant acinus at the bottom-right corner. (DQ IP).
The differential diagnosis between prostatic adenocarcinoma and transitional cell carcinoma is discussed below. Pitfalls and infrequent findings in prostate aspirates, a list of benign conditions mimicking carcinoma and clues to diagnosis have been published elsewhere.9
Grading of adenocarcinoma4,5,27,34,36,37,39
The cytologic presentation is related to the tumor grade. Three grades are recognized.27 Differentiation may vary within the same tumor. Grading is decided by the most malignant pattern seen in available smears, which may not be representative of the whole tumor. Although the correlation between cytological grade and survival has been shown to be very good in a large series of cases,27 most urologists require Gleason grading based on systematic TNCB taken according to a standardized protocol if RP is considered.
Well-differentiated carcinoma may go unnoticed if normal epithelial cells are not present for comparison. The number of cells aspirated tends to be much greater than in samples of BPH, and the amount of background secretion is less. High cellularity on its own may raise a suspicion of malignancy and suggests further investigation by systematic TNCB and serum PSA.
Well-differentiated carcinoma (Fig. 13.5)
Poorly-differentiated carcinoma (Fig. 13.8)
Effects of hormonal treatment and radiotherapy (Fig. 13.15)9,27,31,36,37,39

Fig. 13.15 Prostate, hormonal effect
Metaplastic squamous cells; large glycogenized cells and clusters of epithelial cells, some with enlarged nuclei. Hormonal response in confirmed prostatic adenocarcinoma (DQ, IP).
Transitional cell carcinoma (Figs 13.16 and 13.17)9,37


Fig. 13.16 Transitional cell carcinoma
(A) Pleomorphic malignant cells; hyperchromatic eccentric nuclei; dense cytoplasm (tFNA of prostate; DQ, HP); (B) Corresponding tissue section of transitional cell carcinoma invading the prostate (H&E, IP).

Fig. 13.17 Combined transitional/adenocarcinoma
Aggregate of well-differentiated adenocarcinoma with nuclear crowding and microacinar pattern; adjacent group of larger, more pleomorphic malignant transitional cells (DQ, HP).
Transitional cell carcinoma may invade the prostate from the urinary bladder or it may arise from periurethral ducts within the prostate itself. Coexistence of transitional cell carcinoma and adenocarcinoma of the prostate is not rare (Fig. 13.17). It is important to distinguish transitional cell carcinoma from adenocarcinoma, since the former does not respond to hormonal treatment.
Transitional cell carcinomas involving the prostate are usually deeply invasive, high-grade tumors (see also Figs 12.29–12.31). Squamous differentiation is seen in some tumors, whereas papillary structures are rare.
Problems and differential diagnosis
The distinction from prostatic adenocarcinoma is essential. Cells from a prostatic adenocarcinoma of comparable differentiation show a lesser degree of nuclear pleomorphism, the nuclei are paler, vesicular, and the cytoplasm is indistinct and fragile. The nuclei are also fragile and some are smudged. Microacini can nearly always be found in adenocarcinoma except in truly anaplastic tumors. Palisading at the periphery of cell aggregates from a transitional cell carcinoma should not be mistaken for glandular differentiation. Immunostaining for PSA, PSAP, 34βE12, Uroplakin III and p63 is helpful in difficult cases although interpretation may be troublesome.
Rare tumors of the prostate9
Cytologic descriptions and differential diagnoses of ‘foamy cell carcinoma’, prostatic ductal adenocarcinoma (papillary or endometrioid) (Fig. 13.18), mucinous (colloid), small cell carcinoma, squamous cell carcinoma (Fig. 13.19), metastatic solid tumors within the prostate, and mesenchymal tumors have been described elsewhere.9 The differential diagnosis between ductal cell carcinoma, prostatic adenocarcinoma and transitional cell carcinoma has been discussed. Nuclear grooves are a helpful clue for diagnosis of ductal cell carcinoma.43

Fig. 13.18 Ductal cell adenocarcinoma
A papillary cluster. Notice nuclear palisading and monomorphism ( DQ, HP).

Fig. 13.19 Squamous cell carcinoma of prostate
Clusters of small malignant cells, some showing squamous differentiation including a few orangeophilic cells (center and upper left) (Pap, IP).
A morphologic and immunohistochemical study of small cell carcinomas of the prostate has been published.44 The cytological pattern is similar to small cell tumors in other sites (Fig. 13.20). A review of adenoid cystic/basal cell carcinoma of the prostate has been reported.45 We are not aware of any report of cytological findings of this tumor.


Fig. 13.20 Small cell (neuroendocrine) carcinoma of prostate
(A) Clusters of malignant cells with a high N : C ratio and some nuclear molding (DQ, HP); (B) Tissue section, same case (H&E, IP). Immunostaining for chromogranin was positive.
Rarely, lymphomas may involve the prostate and cause enlargement and clinical symptoms. This could be mistaken for small-cell or anaplastic carcinoma in smears. The diagnosis can be confirmed by immunostaining.
Sarcomas of the prostate are rare. These are mainly rhabdomyosarcomas in children, leiomyosarcomas (Fig. 13.21) or fibrosarcomas in adults (see Chapter 15).9,46
Testis
Clinical aspects
The place of FNA in the investigative sequence
Pathologists attempting cytological diagnosis of testicular masses must be fully conversant with the WHO classification of tumors of the testis12 and with the bewildering patterns shown by these tumors.12,47-49 This is also essential in the proficient identification of extragonadal germ cell tumors, primary and metastatic, in FNA samples.50-56 FNA sampling and subsequent microscopy should ideally be performed by the same pathologist to enable cytological interpretation in the light of clinical findings.14,18
In our hospital, after clinical examination by the urologist, the patient is referred to the clinical cytology unit. The pathologist explains the procedure and obtains a written consent from the patient. A provisional diagnosis of benign or malignant, and if malignant of seminoma versus non-seminoma, is provided to the urologist on site. The whole procedure takes less than 30 minutes. In case of malignancy, orchidectomy follows 3–7 days after diagnosis. Rapid feedback to the urologist is essential.
FNA does not replace histological diagnosis. The aim is mainly to provide a triage of cases of testicular swelling into those who do not require surgery as the first-choice treatment and those who do.14 Seminoma represents about 50% of TGCT and 40–45% of all testicular neoplasms.48 This means that familiarity with the cytologic patterns of seminoma enables the pathologist to identify about 50% of TGCT in FNA samples.
Accuracy of diagnosis
The experience of cytologic features of germ cell tumors (GCT), primary and metastatic, accrued over two decades, permits not only a confident diagnosis of malignancy but also correct tumor typing in most cases.14,50-66 The proper use of FNA of testicular masses reduces the need for surgery considerably.21,58-61 Gupta et al.20 underlined the role of FNA in the differential diagnosis of epididymal nodules, avoiding surgical biopsy and other investigations. See also Chapter 12 in the monograph by Linsk and Franzén,65 and Chapter 4 in that by Zajicek.66
Limitations of FNA of testicular tumors are:14
A few additional specific problems should be emphasized:
Complications
Fine needle aspiration may be painful in benign conditions and in fertility studies. The pain usually irradiates to the homolateral inguinal zone. It subsides in an hour and can be relieved by painkillers. FNA of malignant conditions and acute scrotum syndrome is almost painless. We have seen microscopic hemorrhage and necrosis in the subsequent surgical specimen, possibly caused by the needle, but this has never prevented histological diagnosis.
The only contraindication to testicular FNA mentioned in the literature is acute orchitis accompanied by cellulitis of the scrotum.65
Tumor seeding in the needle track has not been recorded in a number of studies.58,65-67 Tumor stage (TNM) was not modified following FNA in a series of malignant testicular tumors.61 In our experience of more than 120 TGCT with 5–10 years’ follow-up, there has been no evidence of dissemination caused by FNA. The benefit of a rapid and reliable diagnosis of malignancy outweighs the unproven risk of dissemination.
Technical considerations
We do not use local anesthesia for testicular FNA. Infiltration of the spermatic cord has been advocated in sequential aspirations for the evaluation of male infertility and for sperm retrieval.68 We use 25-gauge needles, only exceptionally 23 gauge, and only one or two biopsies with one or two passes each time. US guidance may be helpful in partly cystic tumors, in non palpable US-detected lesions, in cases of retroperitoneal GCT (burnt-out TCGT), and in the follow-up of patients with lymphoma or leukemia.
Adequate training and experience in performing FNA and handling of samples is of paramount importance (see Chapter 2). Some points are of particular importance in testicular tumors. It is essential that the needle remains within the target during aspiration and that the negative pressure is released before withdrawing the needle. Smear pressure must be carefully balanced to avoid crush artifacts, particularly in seminoma. Bloody samples must be smeared quickly and are most often suboptimal.
Gross examination of the samples at smearing often gives valuable hints to the nature of the target lesion (author’s unpublished results). We strongly recommend the parallel use of DQ and Pap staining, but DQ takes preference over Pap stain. We do not use immunocytochemistry routinely in FNA of suspected testicular tumors. We believe that its use exceeds the basic aim of FNA in this field: a triage separating benign from malignant lesions. However, immunostaining for OCT 3/4, EMA, AE1/AE3, S-100, and appropriate lymphoid markers is useful to establish germ cell origin for a metastatic poorly differentiated neoplasm in a young man because of the potential for specific curative chemotherapy.69 Immunostaining for PLAP has been used in an attempt to detect noninvasive testicular cancer in cryptorchid men.70
Cytological findings
The non-neoplastic testis (Figs 13.22 and 13.23)
Smears from normal testicular tissue contain cells which represent all stages of spermiogenesis, from spermatogonia to spermatozoa, in varying proportions. Spermatozoa and late spermatids are easily recognized by the nuclear size, shape and hyperchromasia, whereas the less mature forms resemble lymphoid cells of blastic type, particularly in air-dried DQ-stained smears (Fig. 13.22). Dark and pale spermatogonia can be recognized by their chromatin density, primary spermatocytes in pachytene; the latter are larger and have easily discernible thick, long chromatin threads frequently parallel to each other. Normal spermiogenesis must not be mistaken for lymphoma or TCGT. The presence of normal spermiogenesis excludes neoplasia, unless the target has been missed.

Fig. 13.22 Non-neoplastic testis
Range of spermatogenetic cells including a few mature sperms; note resemblance to lymphoid cells (DQ HP).
Sertoli cells, single or in groups, are easily identified, particularly in smears from atrophic testicular tissue. Sertoli cells have pale, round nuclei, prominent nucleoli and abundant, relatively dense, vacuolated cytoplasm with indistinct borders. They often appear as naked nuclei (Fig. 13.23). Sertoli cells predominate in infancy, cryptorchidism, cirrhosis, infections and following hormonal blockage for prostate cancer. In ‘Sertoli cell only syndrome’ there is a complete absence of the germinal line; this condition cannot be distinguished from diffuse severe atrophy.
Leydig cells are difficult to recognize in FNA smears of normal testis regardless of the staining method. Nuclei are perfectly round and characteristically have one or two eccentric nucleoli. The chromatin pattern is denser than that of Sertoli cells, and the cytoplasm is better defined, dense eosinophilic and granular. Reinke’s crystals are difficult to spot except in Leydig cell tumors.71 Leydig cells predominate in aspirates from patients with Klinefelter’s syndrome. In the appropriate clinical setting, this diagnosis is suggested if smears show abundant Leydig cells and connective tissue strands and absence of cells of germ lineage.
Detailed accounts of the cytology of spermatogenesis as seen in FNA smears were published more than two decades ago.72,73 FNA has achieved great popularity in India and Middle Eastern countries for the study of male infertility.21-23,74-77 It has been used to locate areas of sperm production to guide sperm extraction procedures in men with non-obstructive azoospermia.68,78 An interesting scheme for reporting FNA testicular biopsies has been proposed by Dajani.75 See also Linsk & Franzen65 and Zajicek.66
In acute orchitis.60,65,66 the testicle is swollen and hard, and FNA is painful. Aspirates usually have abundant entangled fibrin threads, leukocytes, histiocytes, debris and fragments of necrotic seminiferous tubules. Chromatin threads may be found (Fig. 13.24).


(A) Two intersected seminiferous tubules filled with necrotic and inflammatory cells; (B) Dirty background, naked nuclei of Sertoli cells, degenerate germinal cells (upper-right corner), tailless spermatozoa and debris (A Pap, LP; B DQ, HP).
Embryonal carcinoma, mixed TGCT and seminoma must be ruled out before making a diagnosis of acute orchitis.
Chronic orchitis66 is a rare condition. Aspirates are scanty due to fibrosis. Lymphocytes, plasma cells, histiocytes and sparse polymorphs may be present.
Granulomatous orchitis60,65,66 (Fig. 13.25) is usually cryptogenic but may be tuberculous or due to other infections. Aspirates resemble chronic orchitis but also include aggregates of epithelioid histiocytes and multinucleated giant cells. Caseous necrosis is frequently seen in tuberculous orchitis.

Fig. 13.25 Granulomatous orchitis
An epithelioid granuloma (left). Notice a primary spermatocyte in the upper-right corner and reactive atypical nuclei at the lower-right corner. (DQ, HP)
Tuberculous orchitis is almost always associated with tuberculous epididymitis, but isolated tuberculous epididymitis does occur. Increased consistency of a mobile epididymis does not suggest tumor, but an enlarged epididymis fixed to the testis as occurs in tuberculous epididymitis can mimic a tumor. Tuberculous orchitis can also mimic testicular malignancy.79 The correct diagnosis of tuberculous epididymitis and epididymo-orchitis may prevent unnecessary orchidectomy.17,25,80
Chronic and granulomatous orchitis must be distinguished from seminoma. Eighty per cent of seminomas contain lymphocytic infiltrates and 50% contain epithelioid granulomas.66 Seminoma may present with a clinical history suggestive of chronic orchitis.66 Seminoma must be ruled out whenever smears contain abundant lymphocytes or epithelioid cells. In our experience, the differential diagnosis between granulomatous orchitis, seminoma and non-Hodgkin lymphoma is easier cytologically than in tissue sections. Spermatic granuloma also enters the differential diagnosis in granulomatous lesions.81
Epididymitis60,66 FNA smears from acute and chronic epididymitis are dominated by inflammatory cells intermingled with sparse epididymal cells, single or forming monolayered sheets. Quite atypical-looking cells may be found, probably representing regenerative atypia (Fig. 13.26). Surgical exploration may be inevitable if the lesion cannot be clearly separated from the testis clinically or radiologically. Tuberculosis should always be considered in epididymal lesions with or without testicular enlargement (see above). FNA provides adequate material for both cytologic and microbiologic examination and avoids orchidectomy.25 We amplify by PCR the highly conserved IS6110 genomic sequence for the identification of Mycobacterium tuberculosis species.


Fig. 13.26 Chronic epididymitis
(A) Cluster of atypical, somewhat degenerate epithelial cells and inflammatory cells (MGG, HP); (B) Corresponding tissue section (H&E, IP).
The role of FNA in the diagnosis of epididymal nodules has been discussed by Gupta et al.20
Miscellaneous
Hydrocele60,65 usually presents as a concentric swelling. The aspirate is pale or dark amber. A pale aspirate is sparsely cellular of just a few mesothelial cells and lymphocytes. A dark amber sample contains numerous cells including polymorphs, typical and reactive mesothelial cells singly or forming three-dimensional balls, histiocytes and debris (Fig. 13.27B) representing a hydrocele of long evolution. If numerous three-dimensional balls with spherical or scalloped borders are seen, a mesothelioma of the tunica vaginalis should be considered. Japko et al. gave the first description of the cytology of malignant mesothelioma of the tunica vaginalis in hydrocele fluid.82

Fig. 13.27 Testicular/epididymal cysts
(A) Spermatocele. Numerous sperms, some nucleated cells, probably sperm precursor cells (Pap, IP). (B) Hydrocele. Clusters of vacuolated and pigmented macrophages (MGG, IP);
Hematocele60,65 aspirates are hemorrhagic and bright or dark red in color. A bright aspirate contains preserved erythrocytes, a dark aspirate lysed erythrocytes and hemosiderophages. Hematoceles are generally secondary to problems of venous drainage, coagulation disorders, or to trauma. The possibility of underlying neoplasia must always be considered and the testis reexamined after evacuation of the fluid with repeat FNA in case of doubt.66
Spermatocele is usually peripheral and may mimic a tumor. The aspirate is typically milky and the presence of numerous immobile spermatozoids, balls of spermatozoids, histiocytes, spermiophages and some monolayered sheets of epididymal cells allows a confident diagnosis (Fig. 13.27A). A spermatocele can often be completely evacuated by FNA, leaving no residual lesion. FNA is both diagnostic and therapeutic in hydroceles, hematoceles and spermatoceles.60
Scrotal hernia presents as a scrotal tumor with negative transillumination. Aspirates contain clusters of typical or reactive mesothelial cells and fibroadipose tissue. Mucosecretory epithelium is usually not seen since the needle generally only penetrates as far as the pre-hernial lipoma. The possibility of teratoma must be considered if mucous and intestinal epithelium is aspirated.60
Spontaneous spermatic cord torsion and testicular trauma60 account for an increasing number of consultations. Cytological findings are very similar. FNA is completely painless and aspirates consist of blood in variable quantity and state of preservation, cell debris and ghost germinal cells. Fragments of necrotic seminiferous tubules may be seen (Fig. 13.28A,B).


(A) A twisted seminiferous tubule filled with debris. (Pap, LP); (B) A cast of a seminiferous tubule with ghost cells (DQ, IP).
Spermatic granuloma smears show inflammatory cells and tailless spermatozoids, epithelioid granulomas and macrophages engulfing spermatozoids. Caseous necrosis is not seen. Neoplasia or benign tumor may be suspected clinically. The differential diagnosis has been discussed above (Fig. 13.29).81
Scrotal epidermal cysts are common, easily recognized on clinical examination. Smears show keratinized or non-keratinized squames, multinucleated foreign body giant cells, polymorphs and histiocytes.
Neoplasms14,58-61,63,65,66
The great majority of malignant testicular tumors are GCT. The cytologic features of TGCT described here are based on our personal experience on FNA of primary testicular tumors.
Since TGCT can include more than one component not all necessarily sampled by FNA, a definitive type-specific diagnosis is generally deferred to histological examination. Familiarity with the cytology of TGCT permits the recognition of extragonadal GCT, mainly in the mediastinum and retroperitoneum. The diagnosis is of great clinical importance since treatment and prognosis are different from that of other malignancies occurring in these sites. The diagnosis may be supported by immunostaining.51,69 Note that spermiogenesis is not seen in satisfactory FNA samples of TGCT.
Detailed accounts of the utility and limitations of FNA at extragonadal sites and of cytologic features of extragonadal GCT have been published.51,52
Seminoma (Figs 13.30 and 13.31)14,50,57-63,65,66


(A) Dispersed cells with large pale nuclei and poorly defined cytoplasm; note ‘tigroid’ background, smudged nuclei and small lymphocytes (MGG, HP); (B) Dispersed cells; moderately pleomorphic vesicular nuclei; single or multiple prominent nucleoli; many scattered lymphocytes (Pap, HP).

Fig. 13.31 Mediastinal seminoma
Smear from large mediastinal mass clinically thought to be thymic carcinoma. Cluster of poorly cohesive, obviously malignant cells and some necrotic debris. Cytoplasmic vacuolation and nuclear fragility suggest malignant germ cell tumor; some lymphocytes present but specific typing not possible. Histology confirmed seminoma (MGG, HP).
Criteria for diagnosis
Seminoma is a highly cellular neoplasm of poorly cohesive cells and little stroma. The presence of a lace-like tigroid background (TB), and the high cellularity including lymphocytes account for the intense navy-blue color of the smears. This may suggest the diagnosis even before microscopic study. Comments about the origin of TB and the distinction from ‘lymphoglandular bodies’ have been made elsewhere.60 TB may go unnoticed in Pap-stained smears, but is more conspicuous in DQ smears (Fig. 13.30). A diagnosis of seminoma should not be based solely on the presence of TB or TB-like material. We have observed TB-like material also in aspirates of embryonal carcinoma. The contrary is also true: seminoma should not be ruled out simply because the pathologist is unable to identify TB.14 Large seminomas may show prominent necrosis. Necrosis is a major cause of false negatives in testicular FNA.59 Tumor giant cells or syncytiotrophoblastic cells may be seen in aspirates of seminoma, but can also be found in embryonal carcinoma, mixed TGCT and in trophoblastic tumors.
The plasmatic membrane is well-defined in seminoma, but it is difficult to see in embryonal carcinoma. When lymphocytes, plasma cells, histiocytes and epithelioid granulomas are abundant and seminoma cells scarce, a diagnosis of granulomatous orchitis may be entertained: the absence of spermatozoids and of the germinal line suggest a seminoma.60
Chromatin trailing may be prominent, particularly if the sample was smeared vigorously. This artifact has no diagnostic value in itself, since it may occur also in embryonal carcinoma, yolk sac tumors, lymphomas and acute orchitis. When the smear is dominated by this artifact, and there are no acute inflammatory cells and no spermatogenesis, the pathologist must search carefully for preserved diagnostic cells. In this situation, a tentative diagnosis of seminoma may be made.14
Lymphocytes, plasma cells and even ‘lymphoglandular bodies’ may be prominent in smears of seminoma and may lead to an erroneous diagnosis of lymphoma. Lymphoblasts may also be mistaken for seminoma cells.
Familiarity with the cytology of testicular seminoma helps in the recognition of extragonadal seminoma and metastatic seminomas (Fig. 13.31). Immunostaining may be of help in doubtful cases.69
Seminomas with a greater degree of cellular pleomorphism, higher mitotic rate and scarce stromal lymphocytes have been called anaplastic seminoma or atypical seminoma.12 These seminomas may be mistaken for embryonal carcinoma.65
Spermatocytic seminoma (Fig. 13.32)14,64

Fig. 13.32 Spermatocytic seminoma
Note evident nuclear size variation, spireme chromatin (half left side) and absence of tigroid substance (DQ, HP).
Criteria for diagnosis
Saran et al.64 have listed the cytomorphological features that distinguish spermatocytic seminoma from classical seminoma. The markers useful in other TGCT are generally negative.12
Embryonal carcinoma (Figs 13.33 and 13.34)14,58-61,63,65,66


Fig. 13.33 Embryonal carcinoma
(A) Adenocarcinoma-like tissue fragment of large malignant cells with large vesicular nuclei, coarse chromatin, prominent nucleoli; prominent cytoplasmic vacuolation (MGG, HP); (B) Fragment of undifferentiated mesenchymal tissue right; cluster of malignant epithelial cells with large vesicular nuclei and prominent large nucleoli (H&E, HP) left.
The vesicular nuclei of embryonal carcinoma are larger and more pleomorphic than those of seminoma, the chromatin is coarse and irregular and nucleoli are large, occasionally huge, and eosinophilic. The cytoplasm is pale and distinctly vacuolated, but not ‘bubbly’. It is not highly fragile and a TB as in seminoma is not seen. Cytoplasmic boundaries are poorly defined (Fig. 13.33). Hemorrhage and tumor necrosis may be prominent and may hamper the identification of diagnostic cells. It is usually not seen in smears of seminoma. Chromatin threads and reticulated material resembling TB can occur. Large syncytiotrophoblastic cells may be found. Prominent lymphoid/plasma cell infiltrates or mucus are not seen. The presence of cellular mesenchyme on its own does not warrant a designation of teratoma (Figs. 13.33B and 13.34).49
Tumors of more than one histologic type (mixed forms) (Figs 13.35 and 13.36)14,60,63,65
While the basic GCT types are infrequent in pure forms they are very frequent in mixed forms. Embryonal carcinoma and teratoma are each present in 47% of cases, and yolk sac tumors in 41%; 40% of TGCT contain varying numbers of syncytiotrophoblastic cells.12

Fig. 13.35 Tumor of more than one histological type (mixed form)
Large bisected tumor occupying most of the enlarged testicle in a male 19 years of age. Note hyalinized, degenerate and cystic areas.


Fig. 13.36 Tumor of more than one histological type (mixed form)
(A) Well-differentiated glandular epithelium (right), large malignant cells similar to embryonal carcinoma (left) (MGG, HP); (B) Corresponding tissue section (A, H&E, IP; B, PAP, IP).
Criteria for diagnosis
The diagnosis of mixed forms is simple when malignant elements of an epithelial nature coexist with clear-cut teratomatous structures. Necrosis may obscure the neoplastic cells and the teratomatous component may be only minor or even absent. This can be explained by its greater cohesion causing under-representation in FNA samples. As a result, the differential diagnosis between mixed TGCT and embryonal carcinoma is sometimes difficult or impossible.14,59-61,65,66 The presence of multinucleated syncytial cells is not diagnostic of choriocarcinoma.
Yolk sac tumor (Figs 13.37 and 13.38)14,53-56,59-61,63
Most cytologic reports are based on FNA performed on metastatic sites. A detailed account of the morphologic spectrum of endodermal sinus tumor has been reported by Akhtar et al.53


Fig. 13.37 Endodermal sinus tumor
(A) Polypoid epithelial fragment of large malignant cells with pale, almost clear, vacuolated cytoplasm (MGG, HP); (B) Corresponding tissue section (H&E, IP).


Fig. 13.38 Endodermal sinus tumor
(A) A glomeruloid cell cluster with vacuolated cytoplasm on a mucoid background (DQ, IP); (B) Cell cluster with a vascular stalk and several hyaline globules.
Pure yolk sac tumors are almost always encountered in infants and young children but rare in the first 6 months of life.49 In adults, this pattern is seen in approximately 40% of nonseminomatous GCT;12 however, it can easily be mistaken for embryonal carcinoma in FNA smears. This is why most reported cases are of metastatic tumors. Hyaline globules and eosinophilic membrane-like material are hints to the diagnosis of this tumor type (Fig. 13.38B). In infants and young children, the aforementioned cytological criteria permit a confident diagnosis by FNA.
Choriocarcinoma (Fig. 13.39)59,63,66
These tumors most commonly present with symptoms referable to metastases12 and most FNA reports are of extratesticular metastases. Immunostaining for βHCG is helpful to identify syncytiotrophoblastic cells. Large syncytiotrophoblastic cells may also be aspirated from classical seminomas, embryonal carcinomas and mixed TGCT.
Teratoma (Fig. 13.40)14,59,63,66



Fig. 13.40 Testicular teratoma
(A) Mature components (squamous and mucus secretory) (Pap, IP); (B) Primitive neuroectoderm; (C) Immature mesenchyma (fetal-like tissue) (B,C; DQ, IP).
Criteria for diagnosis
It is difficult to specify diagnostic criteria for this entity because of the variability of histologic patterns.14,58 In our experience, the main problem is that small foci of embryonal carcinoma may be missed. Organising testicular infarction may lead the unwary to an erroneous diagnosis of teratoma.14 If the needle samples a cystic component of a teratoma, acellular fluid may be obtained, resulting in a false-negative diagnosis. In such cases, the pathologist must reexamine the testis, and any persistent testicular mass must be rebiopsied.
The finding of palisading cylindrical cells and mucus should raise the possibility of a scrotal hernia and this diagnosis should be ruled out before making a diagnosis of mature teratoma. Readers are referred to the monograph by Zajicek66 for descriptions of pure teratoma We reported the cytologic features in a case of epidermoid cyst.83
Sex cord-gonadal stromal tumors
Leydig cell tumor (Fig. 13.41)60,61,66,71

Fig. 13.41 Leydig cell tumor of testis
Isolated naked nuclei with a prominent nucleolus, mild anisokaryosis. (DQ, HP).
Criteria for diagnosis
Numerous Leydig cells may also be obtained from testicles of patients with Klinefelter’s syndrome and from the so-called testicular tumor of the adrenal genital syndrome, but the clinical setting is different.
The finding of intracytoplasmic lipofuscin pigment and several intracytoplasmic as well as intranuclear Reinke’s crystals serve to clinch the diagnosis on FNA.71 Cytologic features do not permit the separation of benign from malignant Leydig cell tumors.
Hematopoietic tumors
The clinicopathological features of primary testicular and paratesticular lymphomas have been described by Al-Abbadi et al.85
Criteria for diagnosis
A malignant lymphoid infiltrate found in FNA of the testis raises three possibilities with different clinical implications: a terminal testicular leukemic or lymphomatous infiltration, the initial manifestation of a previously undiagnosed lymphoma, and a primary testicular lymphoma.
The distinction between testicular lymphoma, seminoma, embryonal carcinoma and granulomatous orchitis is easier in cytologic specimens than in tissue sections. Misinterpretation can occur, especially in cases presenting at an age similar to that for TGCT. Appropriate immunostaining may be of help.
FNA has been used for early detection of testicular involvement and relapse of acute lymphoblastic leukemia in children.86,87 Granulocytic sarcoma may involve the testis; only rarely has this entity been diagnosed by FNA.88
Secondary tumors of the testis
Rarely, metastatic carcinoma may simulate a primary testicular tumor. The origin of the cancer is most often in the lung or the prostate. We have seen a gastric signet ring cell carcinoma metastatic to the testis. A clinicopathological analysis of 26 cases has been recently published.89
Tumors of paratesticular structures
Adenomatoid tumor ( Fig. 13.42)90

Clusters of plump spindle cells resembling mesothelial cells; abundant well-defined cytoplasm; a few vacuoles; mild nuclear atypia (A, DQ; B, Pap, HP).
Criteria for diagnosis
The clinicocytologic presentation of adenomatoid tumors is unique and easily recognized by FNA cytology, which permits its differentiation from primary testicular neoplasms.90 However, the diagnosis of adenomatoid tumor can be problematic in an atypical location as it may be mistaken for seminoma.24
Mesothelioma (Fig. 13.43)
We have studied two cases displaying cytological features similar to those found in pleural effusions. The main differential diagnoses are longstanding hydrocele with reactive mesothelial cells forming numerous three-dimensional balls, and metastastic carcinoma. FNA findings in intrascrotal mesothelioma have been described in a few cases, some with a well-documented history of asbestos exposure.82,91,92 The immunohistochemical profile of malignant mesotheliomas of the tunica vaginalis has been reported.93
Other tumors
Liposarcoma and leiomyosarcoma are the most common sarcomas of the scrotum in adults, paratesticular rhabdomyosarcoma in children.12 A few case reports with FNA have been published.19,67,94,95 The cytology of a congenital malignant rhabdoid tumor has been described.96 Paratesticular sarcomas may mimic a primary testicular tumor clinically and ultrasonographically. FNA is helpful to rule out a TGCT.19,67,94,96
The cytologic findings of a testicular papillary serous cystadenoma have recently been described.97
A case of primary melanoma of scrotum in 55-yr-old man diagnosed by FNA has been reported.98
Penis
Primary squamous cell carcinoma of the penis can be diagnosed by scrape smears directly from the surface of the lesion. Secondary carcinoma involving the deeper tissues of the shaft of the penis from primary tumors in the prostate or bladder can be diagnosed by FNA using a 25–27-gauge needle. This is well tolerated by patients without significant complications. A series of FNA of penile lesions have been reported by Skoog et al.99
Clinical aspects
The place of FNAC in the investigative sequence
The main use of FNAC in gynecological practice is in the investigation of suspected pelvic recurrence or metastasis in patients treated for gynecological cancer. A palpable mass in the vaginal vault or in the pelvic tissues detected during routine follow-up and clinically suspicious of recurrent tumor may simply be due to local edema, inflammation or repair. FNAC is the simplest and least invasive method of biopsy confirmation in these circumstances.100-103
The role of FNAC in the preoperative investigation of ovarian tumors and of ovarian cysts at laparoscopy remains controversial mainly due to the proven risk of intraperitoneal seeding.104-108 It is also argued that preoperative biopsy is unnecessary since surgical exploration is mandatory anyway. On the other hand, cytological assessment may allow selective treatment in some cases, for example preoperative irradiation of anaplastic carcinoma.5 Aspirated material can be used for ancillary studies. FNB of the contralateral ovary during laparotomy for ovarian tumor can be of value when preservation of ovarian function is important.6,7 FNB may be considered in patients who are poor surgical risks, have disseminated cancer at presentation or have suspected recurrence of previously diagnosed tumor.
Most ovarian cysts detected at laparoscopy are functional cysts but a few may be neoplastic. Hormonal assay of aspirated cyst fluid helps to distinguish between functional and neoplastic cysts.109-111 Laparoscopic cyst aspiration in conjunction with US findings (size, multiloculation, solid areas) and with hormonal assay can reduce the need for surgery in selected cases.10,112 However, peritoneal dissemination following laparoscopic FNB of cystic carcinoma has been observed.113
Accuracy of diagnosis
Cytological diagnosis of recurrent or metastatic cancer is usually not difficult if samples are adequate, of good quality and contain unequivocally malignant cells, and if the histology of the primary is known. However, postradiation atypia of epithelial or stromal cells can cause problems and full knowledge of any given treatment is essential.114
The diagnostic accuracy of preoperative FNB of ovarian tumors has been reported as 90–95%.5-7 A type-specific diagnosis may not be possible, particularly in ovarian stromal and other uncommon tumors. Accuracy is lower in cystic tumors but can be improved by supplementing cytological examination with biochemical assay. One study showed a high proportion of unsatisfactory samples and a low diagnostic sensitivity for FNB of ovarian cystic lesions, but specificity was high.13
Complications
Septicemia has been recorded following transrectal FNB of cystic ovarian tumors, and a transvaginal approach is therefore favored. As mentioned above, peritoneal seeding of tumor cells can occur following transabdominal FNB of cystadenocarcinoma.14 The true incidence of this serious complication is uncertain, but the risk is real and an extraperitoneal approach should be chosen if malignancy is suspected.5
Technical considerations
The technique described for FNB of the prostate is applicable to any palpable pelvic mass. FNB can be performed as an office procedure, or coordinated with other procedures requiring general anesthesia, such as bimanual palpation, diagnostic curettage or cystoscopy.
Transvaginal puncture is more likely to sample a solid portion of a cystic ovarian tumor than a transabdominal approach.5 The possibility that the aspirate is of peritoneal fluid rather than fluid from a cystic lesion should be considered since the exact position of the needle at biopsy can be difficult to decide. Parallel use of MGG/Diff-Quik and Papanicolaou staining is recommended. Spare smears, cell blocks or liquid-based preparations for special stains and immunostaining may be needed in selected cases.
Cytological findings
Most palpable lesions in the lower female genital tract are accessible to FNB.115 Malignant tumors subjected to FNB are mainly recurrent or metastatic squamous cell carcinomas or adenocarcinomas.1-3 Examples of recurrent carcinoma in the pelvis, retroperitoneum and vaginal vault confirmed by transvaginal FNB are illustrated in Figures 13.44 to 13.46. Malignant melanoma should be remembered in the differential diagnosis of poorly differentiated malignancies.

Fig. 13.44 Adenocarcinoma of uterine cervix
FNA smear of pelvic recurrence. Sheet of atypical glandular epithelial cells; nuclear crowding and overlapping, moderate pleomorphism (MGG; HP).

Fig. 13.45 Retroperitoneal metastasis of adenocarcinoma of fallopian tube
Pattern of moderately differentiated adenocarcinoma without specific features (DQ; HP).

Fig. 13.46 Small-cell neuroendocrine carcinoma vagina
FNA smear of recurrent tumor of the vaginal vault. Irregular clusters of small cells with hyperchromatic nuclei; some nuclear molding (Pap; HP).
Postoperative inflammation and repair may be clinically suspicious of recurrent cancer. Smears from such lesions can be highly cellular, and reactive histiocytes can appear atypical, particularly in air-dried smears. Postradiation atypia of non-neoplastic cells causes diagnostic difficulties in some cases.
Cytological findings in malacoplakia of the vagina have been described.116 Smears show many histiocytes with intracytoplasmic PAS-positive Michaelis-Gutmann bodies. Benign and malignant vulval tumors are easily accessible to FNB.3 The cytological patterns of papillary hidradenoma117 and of adenoid cystic carcinoma of Bartholin’s gland118 have been reported.
Pelvic endometriosis (Fig. 13.47)


Fragments of spindle cell stroma and sheets of glandular epithelium; mild nuclear atypia in (B); (A, Pap; B, MGG; HP).
Endometriosis is a relatively common lesion in the pelvic peritoneum, abdominal wall and genital tract. A history of cyclic symptoms in a premenopausal woman suggests the diagnosis, but it may present as a mass lesion suspicious of neoplasia. The diagnosis is based on the identification of both glandular epithelial cells and spindle stromal cells in the smears. The epithelial component may appear atypical (see Fig. 13.48B), but this should not cause concern in the appropriate setting.119,120
Uterine leiomyoma (Fig. 13.48)
Uterine leiomyomas are not often subjected to FNB. The consistency of the tissue felt through the needle is characteristically hard and tough. Smears are scanty, containing tissue fragments of spindle cells and intercellular collagen, and few single cells. The cells have syncytial eosinophilic cytoplasm and bland nuclei. There are no mitoses and no evidence of necrosis.
The distinction between highly cellular leiomyoma and low-grade leiomyosarcoma may not be possible, since mitotic counts are not reliable in FNB samples.121
Malignant tumors
The primary diagnosis of endometrial adenocarcinoma is made by other means, but FNB may be used to confirm tumor recurrence or metastasis (Fig. 13.49).122

Fig. 13.49 Intermediate-grade endometrial adenocarcinoma
Poorly cohesive malignant epithelial cells; some microglandular groups (MGG, HP).
(Courtesy Dr. J. Klijanienko, Curie Institute, France.)
The cytological findings in uterine leiomyosarcoma are of a spindle cell sarcoma. Smooth muscle differentiation is suggested by a dense, eosinophilic cytoplasm and truncated nuclei, but a type-specific diagnosis should be supported by immunostaining (see Chapter 15). High cellularity, reduced cell cohesion, nuclear pleomorphism, chromatin abnormalities and the presence of necrosis suggest malignancy. Mitotic counts are unreliable in FNB samples.22 Leiomyosarcoma with a round cell epithelioid pattern can be mistaken for carcinoma unless immune marker studies are added (Fig. 13.50).


Fig. 13.50 Uterine leiomyosarcoma
(A) Epithelioid pattern; dispersed, pleomorphic malignant cells of predominantly rounded shape, pale fragile cytoplasm (MGG, HP); (B) Corresponding tissue section; note abnormal mitotic figure (H&E, IP).
FNA smears of endometrial stromal sarcoma are highly cellular.123,124 The cells are plump spindled, eosinophilic with anastomosing cytoplasmic processes. In low-grade tumors (endolymphatic stromal myosis), the cells are relatively small and uniform with bland nuclei, and form cohesive clusters. In high-grade tumors, cells are mainly dispersed and there is no architectural pattern. Nuclei are oval, vesicular, enlarged and moderately pleomorphic, with granular chromatin and small nucleoli. Mitotic figures are frequently observed (Fig. 13.51). Positive staining for CD10 is helpful in the distinction from other spindle cell lesions.


Fig. 13.51 Endometrial stromal sarcoma
(A) Poorly cohesive plump spindle cells with pale ovoid nuclei and small nucleoli; note anastomosing strands of eosinophilic cytoplasm and a few mitoses (H&E, IP); (B) Corresponding tissue section (H&E, IP).
Coexistence of malignant glandular epithelial cells and malignant mesenchymal cells in smears from a uterine or ovarian tumor suggests a malignant mixed Mullerian tumor or carcinosarcoma. A few cases diagnosed by FNB have been reported.125,126 Mesenchymal elements are not often demonstrated in metastatic deposits of this tumor.27
Non-neoplastic ovarian cysts
Simple cysts including surface epithelial inclusion cysts, parovarian and fimbrial cysts, regressing follicular cysts and simple serous cysts, fall into this category. The cysts are lined by a single layer of columnar, cuboidal or flat, sometimes ciliated cells. Aspirated fluid contains mainly ‘cyst macrophages’. These have small central nuclei and abundant well-defined pale, vacuolated cytoplasm often containing hemosiderin pigment. Distinction from degenerate epithelial cells may be difficult. Hormone assay of the cyst fluid can identify functional cysts.8,127
Functional cysts (Fig. 13.52). Kovacic et al.128 have described the cytology of follicular cysts, corpus luteum and theca lutein cysts separately and in detail.

Fig. 13.52 Functional ovarian cysts
(A) Follicular cyst. Loose aggregate of small cells with pale nuclei, indistinct cytoplasm; many apoptotic cells; note mitosis (left) (H&E, HP); (B) Cystic corpus luteum. Papillary-like clusters of cohesive luteinized cells with abundant well-defined cytoplasm (Pap, HP).
Criteria for diagnosis (functional cysts)
The cytological findings are distinctive. The fluid is often cell-rich. Cells are single and in loose clusters. Single cells resemble macrophages. Anisokaryosis may be prominent and nuclear diameter varies from 10 to over 20 microns. Granulosa cell nuclei are rounded, showing only minor irregularities. The chromatin is granular, resembling nuclei of neuroendocrine cells. There are many single apoptotic cells with pyknotic nuclei. Mitotic figures are frequently found (Fig. 13.52A).
Luteinized granulosa cells have a larger amount of dense, granular and vacuolated cytoplasm with better-defined cell borders (Fig. 13.52B). Cells from a corpus luteum are more cohesive, forming solid cords, which can mimic papillary fragments but lack stromal cores. Blood and fibrin are often prominent in the background.
Fluid aspirated from follicular cysts has a high estradiol content.12,28 Intracellular estrogen may also be demonstrated in smears by immunostaining.
Endometriotic cysts. The aspirate usually consists of dark brown fluid or creamy material. Smears show mainly numerous hemosiderin-containing macrophages with a background of altered blood. A specific diagnosis of endometriosis is only possible if epithelial cells and spindle stromal cells are both present in smears (see Fig. 13.47). This is often the case in extraovarian endometriosis but rarely in aspirates from endometriotic cysts. Cell block preparations are useful in this setting, but overall diagnostic specificity of FNA for ovarian endometriosis is low.28 Old blood and hemosiderin-containing macrophages are non-diagnostic, present also in functional cysts, extra-uterine pregnancy and some tumors.
Benign neoplasms
Smears of ovarian fibroma and thecoma are paucicellular, showing a few spindle cells similar to those of uterine leiomyoma. Thecoma cells have plumper and more irregular nuclei and a larger amount of indistinct, fragile cytoplasm. Intracytoplasmic fat droplets are demonstrated by oil-red-O staining of air-dried smears.
We have no personal experience of the cytology of Brenner tumors. The cytological pattern has been described as sheets of epithelial cells of benign appearance with ovoid, grooved (‘coffee bean’) nuclei.6 Extracellular, large, hyaline, eosinophilic globules are characteristic in smears of this tumor. The cytology of a malignant Brenner tumor in a metastatic site has also been reported.129
Smears from benign cystic teratoma (dermoid cyst) show mainly amorphous non-cellular material and some anucleate squames. The presence of fragments of hair shafts and, occasionally, of benign cells from other differentiated tissues supports the diagnosis (Fig. 13.53).130

Fig. 13.53 Benign cystic teratoma
Anucleate squamous cells and a small sheet of benign glandular epithelial cells (lower left); hair shafts, macrophages, debris (Pap, IP).
The finding of keratinous debris or mature squamous cells in FNB samples is equivocal. This may represent contaminant squamous cells from laboratory staff handling, or from the vaginal mucosa in transvaginal FNB.
Cystadenoma, serous and mucinous104,105
Cyst fluid from benign serous cystadenoma of ovary is usually poor in cells, and any cells present are often degenerate or show shrinkage artifacts making a type-specific diagnosis difficult. Cell blocks are often helpful. Well-preserved cells form papillary aggregates, have small, dark, bland nuclei and may have vacuolated cytoplasm (Fig. 13.54). However, papillary tufts of mesothelial cells from the broad ligament closely resemble those of a serous cystadenoma, and may appear atypical if reactive. This possibility must be kept in mind when examining ovarian aspirates. Tall columnar cells with basal nuclei and empty-looking cytoplasm, and viscous mucus in the background suggest mucinous cystadenoma (Fig. 13.55).
Malignant neoplasms5,6,31
Cell-rich smears of serous or mucinous epithelial cells showing nuclear atypia of moderate degree raise a suspicion of malignancy. This is a difficult problem and it is probably not possible to distinguish cytologically between ovarian tumors of ‘borderline’ malignancy and well-differentiated cystadenocarcinoma (Figs 13.56 and 13.57).131 Psammoma bodies are more often a feature of borderline or malignant than of benign serous tumors. Nuclear folds are said to be common in both benign and borderline tumors.132

Fig. 13.56 Serous cystadenoma, ‘borderline’
Clusters of atypical cells showing moderate nuclear enlargement and pleomorphism; some prominent nucleoli; some cytoplasmic vacuoles; psammoma bodies in center left. Histologically borderline serous tumor (Pap, HP).

Fig. 13.57 Mucinous cystadenoma, ‘borderline’
Cohesive sheets of atypical mucin-secreting columnar cells; multilayering and nuclear crowding. Histologically borderline mucinous tumor (MGG, HP).
Serous cystadenocarcinoma (Fig. 13.58)


Fig. 13.58 Serous cystadenocarcinoma
(A) Papillary tissue fragment of crowded atypical glandular cells; large overlapping nuclei; prominent nucleoli; scanty pale cytoplasm (Pap, HP); (B) Cell block. Papillary tumor fragments, psammoma bodies( upper right) (H & E, HP).
The tumor cells generally have a moderate amount of cyanophilic (Pap) cytoplasm, which may be vacuolated but stains negative for mucin. A papillary microarchitectural pattern is not always obvious. Finger-like aggregates of cells with a well-defined border on three sides are more commonly seen than true papillary structures with stromal cores. The microarchitectural pattern is best shown in cell blocks (Fig. 13.58B). Psammoma bodies showing concentric lamellation are a helpful sign when present.
Mucinous cystadenocarcinoma (Fig. 13.59)

Fig. 13.59 Mucinous cystadenocarcinoma
Clusters of pleomorphic malignant glandular cells with a background of mucus (DQ, HP).
Smears are usually cell rich. However, the sample may consist only of mucinous secretion with few cells, mainly mucinophages or bland-looking, spindly epithelial cells similar to those of pseudomyxoma peritonei. The cells resemble those of mucinous cystadenoma but show a variable degree of nuclear enlargement and crowding, an increased N : C ratio and nuclear criteria of malignancy, more obvious in less well-differentiated cancers. The background is of thick, stringy mucus, which stains bluish-violet with MGG. Distinction from metastatic adenocarcinoma may be difficult.
Endometrioid adenocarcinoma (Fig. 13.60)
The cytological features of endometrioid carcinoma are not very specific.23 The cells have an eosinophilic granular cytoplasm and the microarchitectural pattern is glandular, cribriform and partly solid. Mucin is absent or sparse. It may be difficult to distinguish from serous adenocarcinoma, but the main differential diagnosis is metastatic adenocarcinoma, particularly of colonic origin.

Fig. 13.60 Endometrioid carcinoma
Loose cluster of malignant glandular cells with an acinar pattern and some nuclear palisading (MGG, HP).
Immunocytochemistry is helpful in the differential diagnosis between primary ovarian carcinoma and metastatic adenocarcinoma. Primary ovarian carcinoma is usually CK7+, CK20− and CDX2−, whereas colonic cancer is CK7−, CK20+ and CDX2+.
Clear cell carcinoma (Fig. 13.61)
Clear cell carcinoma is an adenocarcinoma in which the cells have abundant, pale, finely granular and vacuolated cytoplasm containing glycogen. The cells form papillary clusters with globoid stromal cores of hyaline, basement membrane-like material (Fig. 13.61B).133 These structures have been called ‘raspberry bodies’ and are of diagnostic significance in ascitic fluid. ‘Hobnail’ cells, as seen in histological sections, may be recognizable also in smears. Nuclear pleomorphism can be relatively mild. The smear background appears ‘tigroid’ and intracytoplasmic glycogen can be demonstrated by PAS-staining of air-dried smears.134
Anaplastic ovarian carcinoma
Anaplastic carcinoma has a very poor prognosis. FNB may allow preoperative radiotherapy for this category of tumors. Anaplastic carcinomas are predominantly solid and aspirates are usually highly cellular. Some evidence of glandular differentiation may be seen. Nuclei are large, pleomorphic and obviously malignant. Large intracytoplasmic, hyaline eosinophilic inclusions similar to those seen in hepatocellular carcinoma may be found.
Metastatic carcinoma to ovary
The possibility of metastatic origin must be considered in all poorly differentiated malignancies. Differential cytokeratin staining is of some help in this distinction. Smears from Krukenberg tumors (ovarian metastasis from gastrointestinal adenocarcinoma) contain signet ring cells, single or small clusters, with intracytoplasmic mucin vacuoles. Cells are usually few due to the abundant fibrous stroma. A CNB may be necessary to provide a confident diagnosis. Malignant melanoma not uncommonly metastasises to the ovary. Criteria for diagnosis are described elsewhere (see Chapter 14).
Gonadal stromal tumors
Granulosa cell tumor (Figs 13.62-13.65)135,136


Fig. 13.62 Granulosa cell tumor
Clusters of cells with some microfollicular groupings; uniformly small round nuclei some with folds; scanty, poorly defined cytoplasm. The globular structures represent the contents of Call-Exner bodies (A, DQ, HP; B, H&E, HP).


Fig. 13.63 Granulosa cell tumor, diffuse pattern
(A) Loose cluster of cells with uniform, ovoid nuclei, some with grooves (Pap, HP); (B) Corresponding tissue section (H&E, IP).

Fig. 13.64 Malignant granulosa cell tumor
Clustered and dispersed cells; suggestion of follicular pattern; pleomorphic nuclei; coarse chromatin; prominent nucleoli; fragile cytoplasm (A, MGG; B, Pap, HP).

Fig. 13.65 Metastasis of granulosa cell tumor to lung
FNB of solitary 2-cm nodule upper lobe left lung in woman age 35 with past history of oophorectomy; cell-rich smear of small cells with round or ovoid uniform nuclei and indistinct cytoplasm; some microfollicular groups (A, DQ, HP; B, immunostaining for inhibin, IP).
Fine needle aspiration smears from granulosa cell tumors of follicular type are highly cellular of both single cells and syncytial aggregates. A follicular pattern is often discernible. In some cases, rounded bodies, 30–100 microns in diameter, of non-cellular material, are present. These probably represent the contents of Call-Exner bodies. They are brightly purple, fibrillar in MGG-stained smears (Fig. 13.62), pale eosinophilic and structureless in H&E. Nuclei are rounded and do not vary much in size. Nuclear grooves (‘coffee bean nuclei’) are frequent, best seen in alcohol-fixed Pap smears. Nuclear chromatin is finely granular and evenly distributed. Nucleoli are small and indistinct. The cells have pale vacuolated cytoplasm with indistinct cell borders. Smears from tumors of the diffuse type are less characteristic. Plump spindle cells predominate, nuclear grooves are present, but there is no characteristic microarchitectural pattern (Fig. 13.63). Immunostaining is helpful: tumor cells are positive for inhibin and vimentin, negative for cytokeratin.
The FNA findings were similar in two examples of malignant granulosa cell tumor but smears were even more cellular and there was marked nuclear pleomorphism. Nuclear chromatin was irregular and nucleoli were prominent (Fig. 13.64). FNA confirmation of granulosa cell tumor supported by markers is possible also in distant metastatic tumor deposits (Fig. 13.65).
Other gonadal stromal tumors of the ovary are rare and there are few reports of FNB diagnosis.137,138
Germ cell tumors
The cytological pattern of ovarian dysgerminoma139 (Fig. 13.66) is identical to that of testicular seminoma (see Fig. 13.30). Cytological findings in endodermal sinus tumor (yolk sac tumor) in the pelvic region in girls have been reported140 and are similar to those of testicular yolk sac tumors (see Fig. 13.37).
1 Franzén S, Giertz G, Zajicek J. Cytological diagnosis of prostatic tumours by transrectal aspiration biopsy: a preliminary report. Br J Urol. 1960;32:193-196.
2 Johening PW. A history of aspiration biopsy with special attention to prostate biopsy. Diagn Cytopathol. 1988;4:265-268.
3 Fox CH. Innovation in medical diagnosis – the Scandinavian curiosity. Lancet. 1979;30:1387-1388.
4 Tannenbaum M, Bostwick DG, Maksem J, et al. The prostate gland. In: Silverberg S, editor. Principles and practice of surgical pathology and cytopathology, 3rd ed. New York: Churchill-Livingston, Inc.; 1997. p. 2321–33
5 Maksen JA, Berner A, Bedrossian C. Fine needle aspiration biopsy of the prostate gland. Diagn Cytopathol. 2007;35:778-785.
6 McWilliam LJ, Roberts ISD, Davies DR. Problems in grading and staging prostatic carcinoma. Current Diagnostic Pathology. 2002;8:65-75.
7 Partin AW, Katan MW, Subong EN, et al. Combination of prostate-specific antigen, clinical stage, and Gleason score to predict pathological state of localized prostate cancer. A multi-institutional update. JAMA. 1997;277:1445-1451.
8 García-Solano J, Sánchez-Sánchez C, Montalbán Romero S, et al. Diagnostic dilemmas in the interpretation of fine-needle aspirates of granulomatous prostatitis. Diagn Cytopathol. 1998;18:215-221.
9 Pérez-Guillermo M, Acosta-Ortega J, García-Solano J. Pitfalls and infrequent findings in fine-needle aspiration of the prostate gland. Diagn Cytopathol. 2005;33:126-137.
10 Pérez-Guillermo M, Acosta-Ortega J, García-Solano J. The continuing role of fine-needle aspiration of the prostate gland into the 21st Century. Diagn Cytopathol. 2005;32:315-320.
11 Berg A, Berner A, Lilleby W, et al. Impact of disseminated tumour cells in patients with non-metastatic prostate cancer treated by definitive radiotherapy. Int J Cancer. 2007;120:1603-1609.
12 Eble JN, Sauter G, Epstein JI, Sesterhenn IA, editors. World Health Organization Classification of Tumours. Pathology and Genetics of Tumours of the Urinary System and Male Genital Organs. Lyon: IARC Press, 2004.
13 Woodward PJ, Sohaey R, O’Donoghue MJ, et al. From the Archives of the AFIP. Tumours and tumourlike lesions of the testis: radiologic-pathologic correlation. AFIP Archives. 2002;22:189-216.
14 García-Solano J, Sánchez- Sánchez C, Montalbán Romero S, et al. Fine needle aspiration (FNA) of testicular germ cell tumours; a 10-year experience in a community hospital. Cytopathology. 1998;9:248-262.
15 Moul JW. Timely diagnosis of testicular cancer. Urol Clin N Am. 2007;34:109-117.
16 Huyghe E, Muller A, Mieusset R, et al. Impact of diagnostic delay in testis cancer: results of a large population-based study. European Urology. 2007;52:1710-1716.
17 Geisinger KR. Tubercular scrotal disease. Acta Cytol. 2006;50:241-242.
18 Pérez-Guillermo M, García-Solano J, Acosta Ortega J. Fine needle aspiration cytology of palpable lesions of the scrotal content. Acta Cytol.. 2008;52:259-260.
19 Daneshbod Y, Monabati A, Kumar PV, et al. Paratesticular spindle cell rhabdomyosarcoma diagnosed by fine needle aspiration cytology: a case report. Acta Cytol. 2005;49:331-334.
20 Gupta N, Rajwanshi A, Srinivasan R, et al. Fine needle aspiration of epididymal nodules in Chandigarh, north India: an audit of 228 cases. Cytopathology. 2006;17:195-198.
21 Handa U, Bhutani A, Mohan H, et al. Role of fine needle aspiration cytology in nonneoplastic testicular and scrotal lesions and male infertility. Acta Cytol. 2006;50:513-517.
22 Han U, Adabag A, Köybasioglu F, et al. Clinical value of cell counts and indices in testicular fine needle aspiration cytology in primary infertility: diagnostic performance compared with histology. Anat Quant Cytol Histol. 2006;28:331-336.
23 Mehrotra R, Chaurasia D. Fine needle aspiration cytology of the testis as the first diagnostic modality in azoospermia: a comparative study of cytology and histology. Cytopathology. 2008;19:363-368.
24 Monappa V, Rao AC, Krishnanand G, et al. Adenomatoid tumour of tunica albuginea mimicking seminoma on fine needle aspiration cytology: a case report. Acta Cytol. 2009;53:349-352.
25 Sah SP, Bhadani PP, Regmi R, et al. Fine needle aspiration cytology of tubercular epididymitis and epididymo-orchitis. Acta Cytol. 2006;50:243-249.
26 Nadji M, Sevin B-U. Pelvic fine needle aspiration cytology in gynecology. In: Linsk JA, Franzén S, editors. Clinical aspiration cytology. 2nd ed. Philadelphia: J.B. Lippincott Co.; 1989:261-282.
27 Esposti P-L. Cytologic malignancy grading of prostatic carcinoma by transrectal aspiration biopsy. A five-year follow-up study of 469 hormone-treated patients. Scand J Urol Nephrol. 1971;5:199-209.
28 Valdman A, Jonmarker S, Ekman P, et al. Cytological features of prostatic intraepithelial neoplasia. Diagn Cytopaythol. 2006;34:317-322.
29 Kaic G, Tomasovic-Loncaric C. alpha-Methylacyl-CoA racemase (AMACR) in fine-needle aspiration specimens of prostate lesions. Diagn Cytopathol. 2009;37:803-808.
30 Planelles Gómez J, Beltrán Armada JM, Alonso Hernández S, et al. Valor de la PAAF transrectal en el diagnóstico del cáncer de próstata en pacientes de edad avanzada. Actas Urol Esp. 2008;32:485-491.
31 Böcking A, Aufferman W. Cytological grading of therapy-induced tumour regression in prostatic carcinoma: proposal of a new system. Diagn Cytopathol. 1987;3:108-111.
32 Waisman J, Adolfsson J, Löwhagen T, et al. Comparison of transrectal prostate digital aspiration and ultrasound-guided core biopsies in 99 men. Urology. 1991;37:301-307.
33 Engelstein D, Mukamel E, Cytron S, et al. Comparison between digitally-guided fine needle aspiration and ultrasound-guided transperineal core needle biopsy of the prostate for the detection of prostate cancer. Br J Urol. 1994;74:210-213.
34 Willems J-S, Lówhagen T. Transrectal fine-needle aspiration biopsy for cytologic diagnosis and grading of prostatic carcinoma. Prostate. 1981;2:381-395.
35 Orell SR. Pitfalls in fine needle aspiration cytology. Cytopathology. 2003;14:173-182.
36 Zajicek J. Prostatic gland and seminal vesicles. In: Wied GL, editor. Aspiration biopsy cytology. Part II. Cytology of infradiaphragmatic organs. Monographs in clinical cytology, Vol 7. Basel: S. Karger; 1979:129-166.
37 Linsk JA, Franzén S. Aspiration biopsy cytology of the prostate gland. In: Linsk JA, Franzén S, editors. Clinical aspiration cytology. 2nd ed. Philadelphia: J.B. Lippincott Co.; 1989:283-304.
38 Esposti P-L, Elman A, Norlén H. Complications of transrectal aspiration biopsy of the prostate. Scand J Urol Nephrol. 1975;9:208-213.
39 Leistenschneider W, Nagel R. Atlas of prostatic cytology. Berlin: Springer-Verlag; 1984.
40 Egevad L. Cytology of the central zone of the prostate. Diagn Cytopathol. 2003;28:239-244.
41 Cazzaniga MG, Tommasini-Denga A, Negri R, et al. Cytologic diagnosis of prostatic malakoplakia. Report of three cases. Acta Cytol. 1987;31:48-52.
42 Mai KT, Roustan Delatour NL, Assiri A, et al. Secondary prostatic adenocarcinoma: a cytopathological study of 50 cases. Diagn Cytopathol. 2007;35:91-95.
43 Vandersteen DP, Wiemerslage SJ, Cohen MB. Prostatic duct adenocarcinoma: a cytologic and histologic case with review of the literature. Diagn Cytopathol. 1997;17:480-483.
44 Wang W, Epstein JI. Small cell carcinoma of the prostate. A morphologic and immunohistochemical study of 95 cases. Am J Surg Pathol. 2008;32:65-71.
45 Begnami MD, Quezado M, Pinto P, et al. Adenoid cystic/basal cell carcinoma of the prostate: review and update. Arch Pathol Lab Med. 2007;131:637-640.
46 Moroz K, Crespo P, de las Morenas A. Fine needle aspiration of prostatic rhabdomyosarcoma. A case report demonstrating the value of DNA ploidy. Acta Cytol. 1995;39:785-790.
47 Bahrami A, Ro JY, Ayala AG. An overview of testicular germ cell tumours. Arch Pathol Lab Med.. 2007;131:1267-1280.
48 Ulbright TM. The most common, clinically significant misdiagnoses in testicular tumour pathology, and how to avoid them. Adv Anat Pathol. 2008;15:18-27.
49 Young RH. Testicular tumours-Some new and a few perennial problems. Arch Pathol Lab Med. 2008;132:548-564.
50 Caraway NP, Fanning CV, Amato RJ, et al. Fine-needle aspiration cytology of seminoma: a review of 16 cases. Diagn Cytopathol. 1995;12:327-333.
51 Collins KA, Geisinger KR, Wakely PEJr, et al. Extragonadal germ cell tumours: a fine-needle aspiration biopsy study. Diagn Cytopathol. 1995;12:223-229.
52 Gupta R, Mathur SR, Arora VK, et al. Cytologic features of extragonadal germ cell tumours. A study of 88 cases with aspiration cytology. Cancer (Cancer cytopathol). 2008;114:504-511.
53 Akhtar M, Ali MA, Sackey K, et al. Fine-needle aspiration biopsy diagnosis of endodermal sinus tumour: Histologic and ultrastructural correlations. Diag Cytopathol. 1990;6:184-192.
54 Afroz N, Khan N, Chana RS. Cytodiagnosis of yolk sac tumour. Indian J Pediatr. 2004;71:939-942.
55 Dominguez-Franjo P, Vargas J, Rodriguez-Peralto JL, et al. Fine needle aspiration biopsy findings in endodermal sinus tumours. A report of four cases with cytologic, immunohistochemical and ultrastructural findings. Acta Cytol. 1993;37:209-215.
56 Mizrak B, Ekinci C. Cytologic diagnosis of yolk sac tumour. A report of seven cases. Acta Cytol. 1995;39:936-940.
57 Fleury-Feith J, Bellot-Besnard J. Criteria for aspiration cytology for the diagnosis of seminoma. Diagn Cytopathol. 1989;5:392-395.
58 Verma K, Raja Tam T, Kapila K. Value of fine needle aspiration cytology in the diagnosis of testicular neoplasma. Acta Cytol. 1989;33:631-634.
59 Balsev E, Francis D, Jacobsen GK. Testicular germ cell tumours. Classification based on fine needle aspiration biopsy. Acta Cytol. 1990;34:690-694.
60 Pérez-Guillermo M, Sola Pérez J. Aspiration cytology of palpable lesions of the scrotal content. Diagn Cytopathol. 1990;6:169-177.
61 Assi A, Patetta R, Fava C, et al. Fine-needle aspiration of testicular lesions: Report of 17 cases. Diagn Cytopathol. 2000;23:388-392.
62 Akhtar M, Ali MA, Huq M, et al. Fine-needle aspiration biopsy of seminoma and dysgerminoma: cytologic, histologic, and electron microscopic correlations. Diagn Cytopathol. 1990;6:99-105.
63 Akhtar M, Al Dayel F. Is it feasible to diagnose germ-cell tumours by fine-needle aspiration biopsy? Diagn Cytopathol. 1997;16:72-77.
64 Saran RK, Banerjee AK, Gupta SK, et al. Spermatocytic seminoma: a cytology and histology case report with review of the literature. Diagn Cytopathol. 1999;20:233-236.
65 Linsk JA, Franzén S. Aspiration biopsy of the testis. In: Linsk JA, Franzén S, editors. Clinical Aspiration Cytology. 2nd ed. Philadelphia: Lippincott; 1989:305-317.
66 Zajicek J. Testis and epididymis. In: Aspiration biopsy cytology. Monographs in clinical cytology. Part 2. Cytology of infradiaphragmatic organs. Basel: Karger; 1979:104-128.
67 Kumar PV, Kazemi H, Khezri A. Testicular embryonal rhabdomyosarcoma diagnosed by fine needle aspiration cytology. A report of two cases. Acta Cytol. 1994;38:573-576.
68 Turek PJ, Cha I, Ljung B-M. Systematic fine-needle aspiration of the testis: correlation to biopsy and results of organ ‘mapping’ for mature sperm in azoospermic men. Urology. 1997;49:743-748.
69 Emerson RE, Ulbright TM. The use of immunohistochemistry in the differential diagnosis of tumours of the testis and paratestis. Seminars in Diagnostic Pathology. 2005:2233-2250.
70 Tavolini IM, Bettella A, Boscolo Berto R, et al. Immunostaining for placental alkaline phosphatase on fine-needle aspiration specimens to detect noninvasive testicular cancer: a prospective evaluation in cryptorchid men. BJU Int.. 2006;97:950-954.
71 Jain M, Aiyer HM, Bajaj P, et al. Intracytoplasmic and intranuclear Reinke’s crystals in a testicular Leydig-cell tumour diagnosed by fine-needle aspiration cytology: a case report with review of the literature. Diagn Cytopathol. 2001;25:162-164.
72 Papic Z, Katona G, Skrabalo Z. The cytologic identification and quantification of testicular cell subtypes. Reproducibility and relation to histologic findings in the diagnosis of male infertility. Acta Cytol. 1988;32:697-706.
73 Schenck U, Schill W-B. Cytology of the human seminiferous epitehelium. Acta Cytol. 1988;32:689-696.
74 Ali MA, Akhtar M, Woodhouse N, et al. Role of testicular fine-needle aspiration biopsy in the evaluation of male infertility: cytologic and histologic correlation. Diagn Cytopathol. 1991;7:128-131.
75 Dajani YF. Testicular biopsy: an update. Current. Diagnostic pathology. 1998;5:17-22.
76 Jain M, Kumari N, Rawat A, et al. Usefulness of testicular fine needle aspiration cytology in cases of infertility. Indian J Pathol Microbiol. 2007;50:851-854.
77 El-Haggar S, Mostafa T, Abdel Nasser T, et al. Fine needle aspiration vs. mTESE in non-obstructive azoospermia. Int J Androl. 2008;31:595-601.
78 Houwen J, Lundin K, Söderlund B, et al. Efficacy of percutaneous needle aspiration and open biopsy for sperm retrieval in men with non-obstructive azoospermia. Acta Obstet Gynecol Scand. 2008;87:1033-1038.
79 Sachdev R, Roy S, Jain S. Tubercular epididymo-orchitis masquerading as testicular malignancy: an interesting case. Acta Cytol. 2008;52:511-512.
80 Garbyal RS, Gupta P, Kumar S, et al. Diagnosis of isolated tuberculous orchitis by fine-needle aspiration cytology. Diagn Cytopathol. 2006;34:698-700.
81 Pérez-Guillermo M, Thor A, Löwhagen T. Spermatic granuloma. Diagnosis by fine needle aspiration cytology. Acta Cytol. 1989;33:1-5.
82 Japko L, Horta AA, Schreiber K, et al. Malignant mesothelioma of the tunica vaginalis testis: report of first case with preoperative diagnosis. Cancer. 1982;49:119-127.
83 Pérez-Guillermo M, García-Solano J, Sánchez-Sánchez C, et al. Diagnostic limitations in testicular cytopathology: to what extent is fine-needle aspiration reliable for the diagnosis of epidermoid cyst of the testis? Diagn Cytopathol.. 2004;31:83-86.
84 Barroca H, Gil-da-Costa MJ, Mariz C. Testicular juvenile granulosa cell tumour: a case report. Acta Cytol. 2007;51:634-636.
85 Al-Abbadi MA, Hattab EM, Tarawneh M, et al. Primary testicular and paratesticular lymphoma. A retrospective clinicopathologic study of 34 cases with emphasis on differential diagnosis. Arch Pathol Lab Med. 2007;131:1040-1046.
86 Akhtar M, Ali MA, Burgess A, et al. Fine-needle aspiration biopsy (FNAB) diagnosis of testicular involvement in acute lymphoblastic leukemia in children. Diagn Cytopathol. 1991;7:504-507.
87 Kumar PV. Testicular leukemia relapse Fine needle aspiration findings. Acta Cytol. 1998;42:312-316.
88 Suh YK, Shin HJ. Fine-needle aspiration biopsy of granulocytic sarcoma: a clinicopathologic study of 27 cases. Cancer. 2000;90:364-372.
89 Ulbright TM, Young RH. Metastatic carcinoma to the testis. A clinicopathologic analysis of 26 nonincidental cases with emphasis on deceptive features. Am J Surg Pathol. 2008;32:1683-1693.
90 Pérez-Guillermo M, Thor A, Löwhagen T. Paratesticular adenomatoid tumours. The cytologic presentation in fine needle aspiration biopsies. Acta Cytol. 1989;33:6-10.
91 Fukunaga M. Well-differentiated papillary mesothelioma of the tunica vaginalis: A case report with aspirate cytologic, immunohistochemical, and ultrastructural studies. Pathol Res Pract (2009), doi 10.1016/j.prp.2009.02.006
92 Mathur SR, Aron M, Gupta R, et al. Malignant mesothelioma of tunica vaginalis: a report of 2 cases with preoperative cytologic diagnosis. Acta Cytol. 2008;52:740-743.
93 Winstanley AM, Ladon G, Berney D, et al. The immunohistochemical profile of malignant mesotheliomas of the tunica vaginalis. Am J Surg Pathol. 2006;30:1-6.
94 Reis-Filho JS, Schmitt FC, Soares MF, et al. Fine needle aspiration cytology of paratesticular rhabdomyosarcoma mimicking a testicular germ cell tumour. Acta Cytol. 2002;46:787-789.
95 Valeri RM, Papanikolaou A, Panagiotou A, et al. A rare case of paratesticular embryonal rhabdomyosarcoma diagnosed by fine needle aspiration: a case report. Acta Cytol. 2009;53:319-322.
96 Salamanca J, Rodríguez-Peralto JL, Azorín D, et al. Paratesticular congenital malignant rhabdoid tumour diagnosed by fine-needle aspiration cytology. A case report. Diagn cytopathol. 2004;30:46-50.
97 Kumar PV, Shirazi M, Salehi M. A diagnostic pitfall of fine needle aspiration cytology in testicular papillary serous cyst adenoma. Acta Cytol. 2009;53:467-470.
98 Damala K, Tsanou E, Pappa L, et al. A rare case of primary malignant melanoma of the scrotum diagnosed by fine-needle aspiration. Diagn Cytopathol.. 2004;31:413-416.
99 Skoog L, Collins BT, Tani E, et al. Fine needle aspiration cytology of penile tumors. Acta Cytol. 1998;42:1336-1340.
100 Wojcik EM, Selvaggi SM, Johnson SC, et al. Factors influencing fine-needle aspiration cytology in the management of recurrent gynecological malignancies. Gynecol Oncol. 1992;46:281-286.
101 Dey P, Dhar KK, Nijhawan R, et al. Fine needle aspiration biopsy in gynecological malignancies. Recurrent and metastatic lesions. Acta Cytol. 1994;38:698-701.
102 Nadji M, Defortuna S, Sevin B-U, et al. Fine-needle aspiration cytology of palpable lesions of the lower female genital tract. Int J Gynecol Pathol. 1994;13:54-61.
103 Ylagan LR, Mutch DG, Dávila RM. Transvaginal fine needle aspiration biopsy. Acta Cytol. 2001;45:927-930.
104 Kjellgren O, Ångström T. Transvaginal and transrectal aspiration biopsy in diagnosis and classification of ovarian tumours. In: Zajicek J, editor. Aspiration biopsy cytology. Part 2. Cytology of infradiaphragmatic organs. Basel: Karger, 1979.
105 Ramzy I, Delaney M. Fine needle aspiration of ovarian masses. I. Correlative cytologic and histologic study of coelomic epithelial neoplasms. Acta Cytol. 1979;23:97-104.
106 Ganjei P. Fine-needle aspiration cytology of the ovary. Clin Lab Med. 1995;15:705-726.
107 Ganjei P, Dickinson B, Harrison TA, et al. Aspiration cytology of neoplastic and non-neoplastic ovarian cysts: is it accurate? Int J Gynecol Pathol. 1996;15:94-101.
108 Granados R. Aspiration cytology of ovarian tumors. Curr Opin Obstet Gynecol. 1995;7:43-48.
109 Wojcik EM, Selvaggi SM. Fine-needle aspiration cytology of cystic ovarian lesions. Diagn Cytopathol. 1994;11:9-14.
110 Kreuger GF, Paradowski T, Wurche K-D, et al. Neoplastic or nonneoplastic ovarian cyst? The role of cytology. Acta Cytol. 1995;39:882-886.
111 Allias F, Chanoz J, Blache G, et al. Value of ultrasound-guided fine-needle aspiration in the management of ovarian and parovarian cysts. Diagn Cytopathol. 2000;22:70-80.
112 Martínez-Onsurbe P, Villaespesa AR, Anquela JMS, et al. Aspiration cytology of 147 adnexal cysts with histologic correlation. Acta Cytol. 2001;45:941-947.
113 Trimbos JB, Hacker NF. The case against aspirating ovarian cysts. Cancer. 1993;72:828-831.
114 Nadji M, Greening SE, Sevin BU, et al. Fine needle aspiration cytology in gynecologic oncology. II. Morphologic aspects. Acta Cytol. 1979;23:380-388.
115 Taylor IW. Biopsy of lesions of the female genital tract in the ambulatory setting. J Long Term Eff Med Implants. 2004;14:185-199.
116 Saad AJ, Donovan TM, Truang LD. Malakoplakia of the vagina diagnosed by fine-needle aspiration cytology. Diagn Cytopathol. 1993;9:559-561.
117 Rollins SD. Fine-needle aspiration diagnosis of a vulvar papillary hidradenoma. A case report. Diagn Cytopathol. 1994;10:60-61.
118 Yamagiwa S, Niwa K, Yokoyama Y, et al. Primary adenoid cystic carcinoma of Bartholin’s gland. A case report. Acta Cytol. 1994;38:79-82.
119 Fulciniti F, Caleo A, Lepore M, et al. Fine needle cytology of endometriosis. Experience with 10 cases. Acta Cytol. 2005;49:495-499.
120 Catalina-Fernandez I, Lopez-Presa D, Saenz-Soutamaria J. Fine needle aspiration cytology in cutaneous and subcutaneous endometriosis. Acta Cytol. 2007;51:380-384.
121 Barbazza R, Chiarelli S, Quintarelli GF, et al. Role of fine-needle aspiration cytology in the preoperative evaluation of smooth muscle tumors. Diagn Cytopathol. 1997;16:326-330.
122 Fulciniti F, Losito NS, Botti G, et al. Cytology of metastatic endometrioid neoplasms: Experience with eight cases. Diagn Cytopathol. 2009;37:347-352.
123 Yang GC. Fine needle aspiration cytology of low grade endometrial stromal sarcoma. Acta Cytol. 1995;39:701-705.
124 Policarpio-Nicolas ML, Cathro HP, Kerr SE, et al. Cytomorpologic features of low-grade endometrial stromal sarcoma. Am J Clin Pathol. 2007;128:265-271.
125 Donat EE, McCutcheon JM, Alper H. Malignant mixed Müllerian tumor of the ovary. Report of a case with cytodiagnosis by fine needle aspiration. Acta Cytol. 1994;38:231-234.
126 Mourad WA, Sneige N, Katz RL, et al. Fine-needle aspiration cytology of recurrent and metastatic mixed mesodermal tumors. Diagn Cytopathol. 1994;11:328-332.
127 Mulvany N, Östör A, Teng G. Evaluation of estradiol in aspirated ovarian cystic lesions. Acta Cytol. 1995;39:663-668.
128 Kovacic J, Rainer S, Levicnik A, et al. Cytology of benign ovarian lesions in connection with laparoscopy. In: Zajicek J, editor. Aspiration biopsy cytology. Part 2. Cytology of infradiaphragmatic organs. Basel: Karger, 1979.
129 Khajuria A, Karmakar T, Srinivasan R. Fine needle aspiration cytology of a subcutaneous metastasis of a malignant Brenner tumor of the ovary: a case report. Acta Cytol. 1995;39:246-248.
130 Ramzy I, Delaney M, Rose P. Fine needle aspiration of ovarian masses. II. Correlative cytologic and histologic study of non-neoplastic cysts and non-coelomic epithelial neoplasms. Acta Cytol. 1979;23:185-193.
131 Athanassiadou P, Grapsa D. Fine needle aspiration of borderline ovarian lesions. Is it useful? Acta Cytol. 2005;49:278-285.
132 Hirokawa M, Miyake Y, Shimizu M, et al. Nuclear findings of ovarian surface epithelial tumors. Diagn Cytopathol. 2000;22:27-29.
133 Atahan S, Ekinci C, Içli F, et al. Cytology of clear cell carcinoma of the female genital tract in fine needle aspirates and ascites. Acta Cytol. 2000;44:1005-1009.
134 Khunamornpong S, Thorner PS, Suprasert P, et al. Clear cell adenocarcinoma of the female genital tract: Tigroid background in various types of cytologic specimen. Diagn Cytopathol. 2005;32:336-340.
135 Lal A, Bourtsos EP, Nayar R, et al. Cytologic features of granulosa cell tumors in fluids and fine needle aspiration specimens. Acta Cytol. 2004;48:315-320.
136 Ali S, Gattuso P, Howard A, et al. Adult granulosa cell tumor of ovary: Fine-needle-aspiration cytology of 10 cases and review of literature. Diagn Cytopathol. 2008;36:292-302.
137 Ramzy I, Delaney M. Signet-ring cell stromal tumour of ovary. Cytologic appearances of fine needle aspiration biopsy. Acta Cytol. 1977;21:14-17.
138 Ryan LJ, Pambuccian SE, Lai R, et al. Endoscopic US-guided fine needle aspiration diagnosis of metastatic sex cord tumor with annular tubules. Diagn Cytopathol. 2006;34:576-579.
139 Hees K, de Jonge JPA, von Kortzfleisch DHJ. Dysgerminoma of ovary. Cytologic, histologic and electron microscopic study of a case. Acta Cytol. 1991;35:341-344.
140 Mizrak B, Ekinci C. Cytologic diagnosis of yolk sac tumor. A report of seven cases. Acta Cytol. 1995;39:936-940.






 .
.






